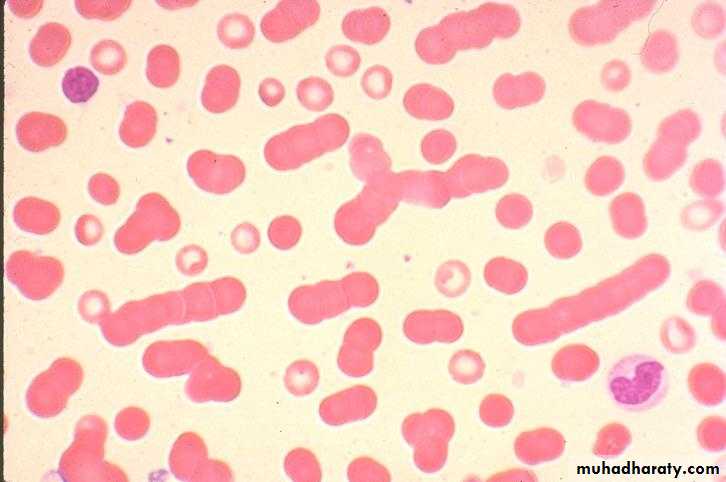
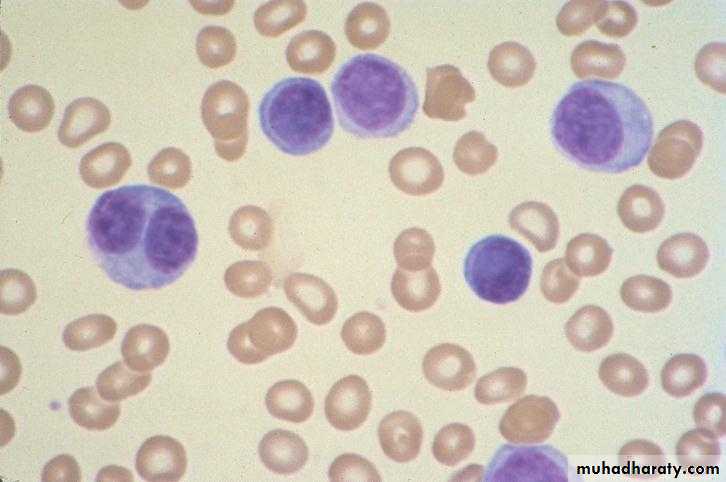

Blood film showing marked rouleaux formation
16Bone marrow showing extensive infiltration by plasma cells
Describe the changes in the BM smear?Increased number of plasma cells in the BM
Normal marrow cells are largely replaced by plasma cells, including atypical binucleated forms, prominent nucleoli, and cytoplasmic droplets containing immunoglobulin.
Multiple myeloma BM aspirate